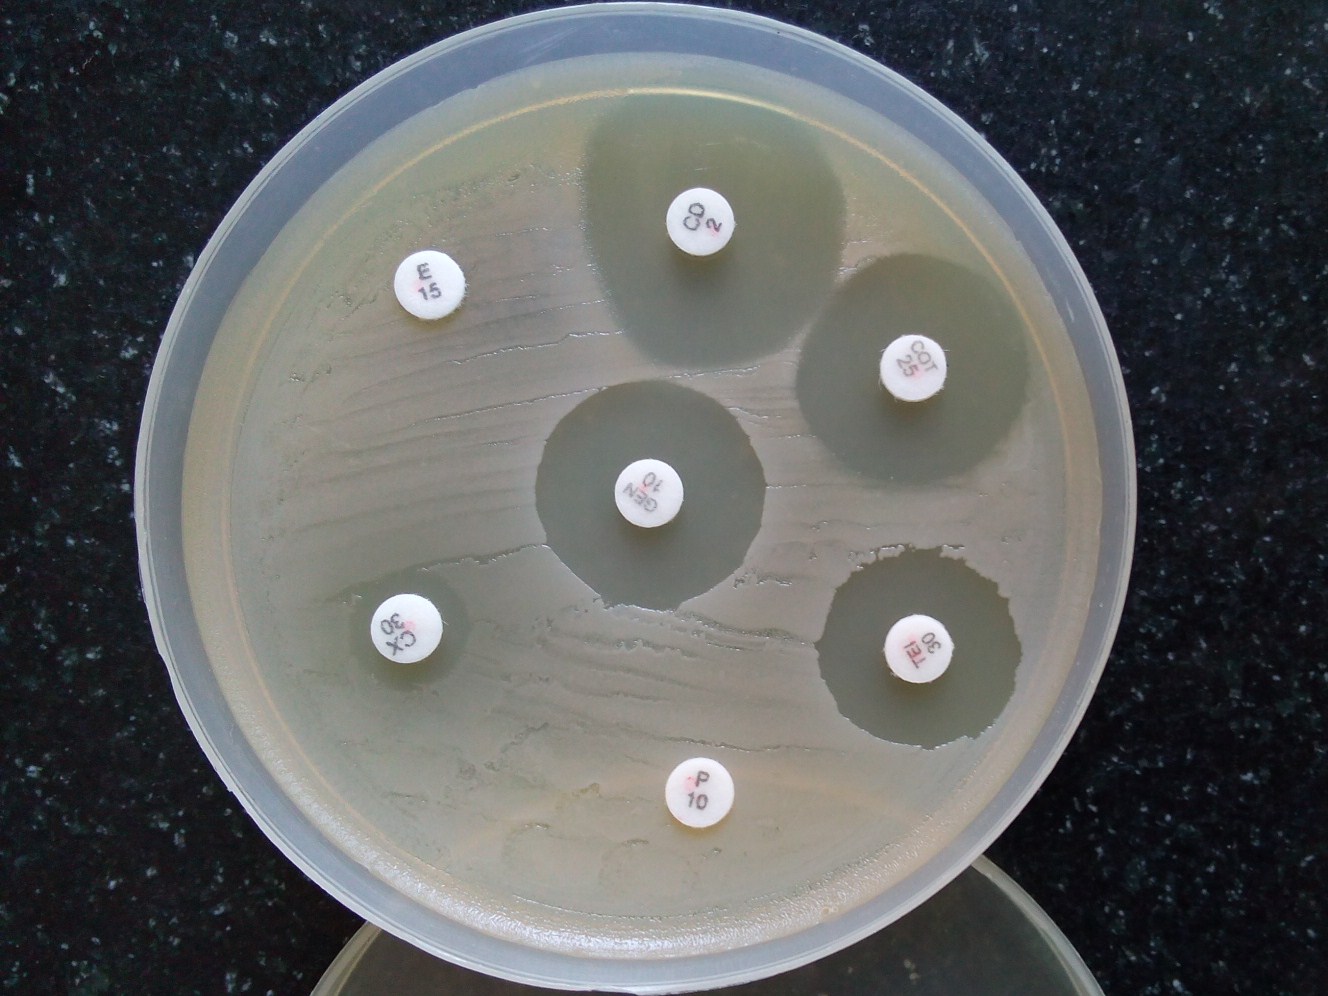

클린다마이신
"오늘의AI위키"의 AI를 통해 더욱 풍부하고 폭넓은 지식 경험을 누리세요.
1. 개요
클린다마이신은 혐기성 세균 감염, 특히 치과 감염, 호흡기, 피부, 연조직 및 복막염 치료에 사용되는 항생제이다. 페니실린 과민증 환자에게는 호기성 세균 감염 치료에도 사용될 수 있으며, 여드름 치료를 위한 국소 투여도 가능하다. 클린다마이신은 그람 양성균, 혐기성 세균 및 일부 기생충 감염에 효과가 있으며, 말라리아, 톡소플라스마증, 폐포자충 폐렴 치료에도 사용된다. 부작용으로는 설사, 위막성 대장염, 피부 자극 등이 있으며, 신경근 차단제의 효과를 연장시킬 수 있다. 클린다마이신은 린코마이신에서 유래한 반합성 유도체이며, 전신 및 국소 제형으로 제공되며 제네릭 의약품으로 저렴하게 구입할 수 있다. 또한 수의학에서도 사용된다.
더 읽어볼만한 페이지
- 여드름 치료제 - 황
황은 주기율표 16족에 속하는 노란색 비금속 원소로, 아미노산, 단백질 등 생물체 구성 성분이며 황산, 비료, 화약 등 화학 산업에서 널리 사용된다. - 여드름 치료제 - 글리콜산
글리콜산은 1851년 최초로 합성된 가장 간단한 α-하이드록시산(AHA)으로, 사탕수수 등에서 발견되며 섬유 산업, 유기 합성, 화장품 산업에 사용되지만 고농도 사용 시 피부 자극을 유발할 수 있고 독극물로 지정되어 관리된다. - 싸이오에터 - 몬테루카스트
몬테루카스트는 류코트리엔 수용체 길항제로서 천식, 알레르기성 비염, 두드러기 같은 알레르기 질환 치료에 사용되지만, 신경정신과적 부작용 위험으로 인해 블랙 박스 경고가 추가되었다. - 싸이오에터 - 메티오닌
메티오닌은 황을 포함하는 필수 아미노산으로, 단백질 구성, 번역 개시, 생화학적 과정에 관여하며 인체 내에서 합성되지 않아 음식으로 섭취해야 하고 결핍 시 건강 문제가 발생할 수 있다.
| 클린다마이신 - [화학 물질]에 관한 문서 | |
|---|---|
| 일반 정보 | |
![]() | |
![]() | |
| 상품명 | 클레오신, 클리나신, 달라신, 기타 |
| 약물 정보 | |
| MedlinePlus | a682399 |
| DailyMedID | Clindamycin |
| 임신 범주 (호주) | A |
| 투여 경로 | 경구, 국소, 정맥 주사, 질내 |
| 약물 분류 | 린코사미드 계열 항생제 |
| ATC 코드 | J01FF01 |
| 법적 규제 현황 | |
| 호주 | S4 |
| 캐나다 | 처방전 필요 |
| 영국 | POM (Prescription Only Medicine, 전문의약품) |
| 미국 | 처방전 필요 |
| 약동학적 정보 | |
| 생체 이용률 | 90% (경구), 4–5% (국소) |
| 단백질 결합률 | 95% |
| 대사 | 간 |
| 반감기 | 2–3 시간 |
| 배설 | 담관 및 콩팥(약 20%) |
| 화학 정보 | |
| CAS 등록번호 | 18323-44-9 |
| PubChem | 446598 |
| DrugBank | DB01190 |
| ChemSpider ID | 393915 |
| UNII | 3U02EL437C |
| KEGG | D00277 |
| ChEBI | 3745 |
| ChEMBL | 1753 |
| IUPAC 명칭 | methyl 7-chloro-6,7,8-trideoxy-6-{[(4R)-1-methyl-4-propyl-L-prolyl]amino}-1-thio-L-threo-α-D-galacto-octopyranoside |
| 분자식 | C18H33Cl N2 O5 S |
| SMILES | Cl[C@@H](C)[C@@H](NC(=O)[C@H]1N(C)C[C@H](CCC)C1)[C@H]2O[C@H](SC)[C@H](O)[C@@H](O)[C@H]2O |
| StdInChI | 1S/C18H33ClN2O5S/c1-5-6-10-7-11(21(3)8-10)17(25)20-12(9(2)19)16-14(23)13(22)15(24)18(26-16)27-4/h9-16,18,22-24H,5-8H2,1-4H3,(H,20,25)/t9-,10+,11-,12+,13-,14+,15+,16+,18+/m0/s1 |
| StdInChIKey | KDLRVYVGXIQJDK-AWPVFWJPSA-N |
| 동의어 | 7-클로로-린코마이신, 7-클로로-7-데옥시린코마이신 |
| 기타 | |
| 상품명 (다른 언어) | Cleocin, Clinacin, Dalacin, others |
2. 의학적 용도
클린다마이신은 주로 혐기성 세균에 의해 발생하는 감염, 특히 치과 감염[17]과 호흡기, 피부, 연조직 감염, 그리고 복막염[18] 치료에 사용된다. 페니실린 과민성이 있는 사람들에게는 감수성 있는 호기성 세균 감염 치료에도 사용될 수 있다. 또한 황색포도상구균에 의한 골 및 관절 감염 치료에도 사용된다.[18][19]
클린다마이신은 열대열 말라리아 치료에 클로로퀸 또는 퀴닌과 함께 사용 시 효과적이며, 특히 어린이와 클로로퀸 내성이 흔한 지역의 임산부에게 유용하다.[30][31] 그러나, 작용이 느리므로 단독으로 사용해서는 안 된다.[30][31]
독성 쇼크 증후군이 의심되는 경우, 반코마이신과 함께 사용되어 독소 생성을 억제한다.[33][34] 임신 초기 세균성 질염 치료에 사용되어 조산 위험을 낮추고,[37] 바베시아증에는 퀴닌과 함께 사용된다.[38] 톡소플라스마증[62][39][40]과 폐포자충 지로베치 폐렴[41] 치료에도 사용된다.
그 외에도, 흡인성 폐렴, 구강 내 감염증, 인두염, 부비동염, 복강 내 감염증, 지역사회 획득형 MRSA(CA-MRSA) 감염증, 피부 감염증, 중이염, 외이염, 턱뼈 주변의 봉와직염, 창상 감염증 등에도 사용될 수 있다. 다만, 중추신경계로의 이행은 극히 낮아 혐기성 세균에 의한 뇌농양·수막염 등에는 사용되지 않는다.
2. 1. 여드름
클린다마이신 인산염의 국소 투여는 경증 또는 중등도 여드름 치료에 사용될 수 있다.[20][21]
여드름 치료를 위해 국소 클린다마이신과 벤조일 과산화물을 장기간 병용하는 것은 살리실산과 벤조일 과산화물을 병용하는 것과 유사했다.[21][22] 국소 클린다마이신과 국소 벤조일 과산화물의 병용은 국소 클린다마이신 단독 사용보다 더 효과적이다.[21][22]
2. 2. 감수성 있는 세균
클린다마이신은 주로 감수성 있는 혐기성 세균에 의해 발생한 감염, 특히 치과 감염[17], 호흡기, 피부, 연조직, 그리고 복막염 치료에 사용된다.[18] 페니실린에 과민성을 보이는 사람들에게는 클린다마이신이 감수성 있는 호기성 세균에 의해 발생한 감염 치료에도 사용될 수 있다. 또한, 특히 ''황색포도상구균''에 의해 발생한 골 및 관절 감염을 치료하는 데에도 사용된다.[18][19]다음 종류의 미생물 감염에 가장 효과적이다.[62]
- 호기성 그람 양성 구균, 여기에는 일부 ''포도상구균'' 및 ''연쇄상구균''(예: 폐렴구균) 속이 포함되지만, 장구균은 포함되지 않는다.
- 혐기성, 그람 음성 간균, 여기에는 일부 ''Bacteroides'', ''Fusobacterium'', 및 ''Prevotella''가 포함되지만, ''Bacteroides fragilis''에서는 내성이 증가하고 있다.[23]
대부분의 호기성 그람 음성 세균(예: ''Pseudomonas'', ''Legionella'', ''Haemophilus influenzae'' 및 ''Moraxella'')은 클린다마이신에 내성이 있으며,[62][24] 통성 혐기성 장내세균과도 마찬가지이다.[25] 주목할 만한 예외는 클린다마이신이 최우선 선택 약물인 ''Capnocytophaga canimorsus''이다.[26]
다음은 몇 가지 의학적으로 중요한 병원균에 대한 MIC 감수성 데이터이다.[27]
그람 양성 균 배양체의 클린다마이신 감수성 검사 시, 특정 표현형을 가진 세균의 하위 집단이 존재하는지 확인하기 위해 "D-test"를 수행하는 것이 일반적이다. D-test를 수행하기 위해, 문제가 되는 세균으로 한천 배지를 접종하고, 에리스로마이신과 클린다마이신이 함유된 두 개의 디스크를 배지에서 15–20 mm 간격으로 배치한다. 클린다마이신 디스크 주변의 억제 구역이 D자 모양이면 검사 결과는 양성이다. 에리스로마이신이 없을 때 클린다마이신에 대한 겉보기 감수성에도 불구하고, D-test 양성은 클린다마이신의 치료적 사용을 배제한다.[29]
클린다마이신 디스크 주변의 억제 구역이 원형이면 검사 결과는 음성이며 클린다마이신을 사용할 수 있다.[29]
2. 3. 기타 용도
클린다마이신은 열대열 말라리아 치료에 클로로퀸 또는 퀴닌과 함께 사용 시 효과적이며 내약성이 좋다. 이 조합은 특히 어린이와 클로로퀸 내성이 흔한 지역의 임산부에게 유용하다.[30][31] 그러나, 작용이 느리므로 단독으로는 항말라리아제로 사용해서는 안 된다.[30][31] 페루 아마존에서 분리된 ''열대열 말라리아''는 ''시험관 내''에서 클린다마이신에 내성을 보였다.[32]메티실린 내성 ''황색포도상구균'' (MRSA)에 의한 피부 및 연조직 감염에 유용할 수 있다.[4] 많은 MRSA 균주가 클린다마이신에 감수성을 보이지만, 미국에서는 내성이 증가하는 추세이다.
독성 쇼크 증후군이 의심되는 경우, 살균제인 반코마이신과 함께 사용된다.[33] 이는 클린다마이신이 독소 합성을 억제하고, 외독소 생성을 감소시키며, 세균 표면 구조를 변화시켜 면역 체계에 더 민감하게 만들기 때문이다.[34][35][36]
임신 초기에 세균성 질염 진단을 받은 여성의 조산 위험을 낮추는 것으로 입증되었다.[37]
바베시아증의 표준 치료법은 클린다마이신과 퀴닌의 조합이다.[38]
톡소플라스마증 치료에도 사용될 수 있으며,[62][39][40] 프리마퀸과 함께 사용하면 경증에서 중등도의 ''폐포자충 지로베치'' 폐렴 치료에 효과적이다.[41]
피부에 바르거나 경구 복용하여 화농성 한선염에도 사용할 수 있다.[42]
그 외에, 흡인성 폐렴, 구강 내 감염증, 페니실린 알레르기가 있는 경우의 인두염이나 부비동염, 복강 내 감염증, CA-MRSA(지역사회 획득형 MRSA) 감염증, 표재성 피부 감염증, 심재성 피부 감염증, 중이염, 외이염, 턱뼈 주변의 봉와직염, 창상 감염증 등에도 사용될 수 있다.
3. 부작용
클린다마이신을 전신 투여했을 때 흔하게(1% 이상) 나타나는 약물 이상 반응으로는 설사, 위막성 대장염, 메스꺼움, 구토, 복부 통증, 경련, 발진 등이 있다. 고용량(정맥 및 경구 투여 모두)에서는 금속성 맛이 나타날 수 있다. 국소 제형을 사용했을 때 흔하게(10% 이상) 나타나는 부작용으로는 피부 건조, 작열감, 가려움증, 비늘, 벗겨짐(로션, 용액), 홍반(폼, 로션, 용액), 기름짐(젤, 로션) 등이 있다. 접촉 피부염이 나타나기도 한다.[43][44] 질 내 투여 시 흔하게(10% 이상) 진균 감염이 발생할 수 있다.
드물게(0.1% 미만) 클린다마이신 치료 중 아나필락시스, 혈액 이상증, 다발성 관절염, 황달, 간 효소 수치 상승, 신장 기능 부전, 심정지, 간독성 등이 나타날 수 있다.[43]
3. 1. ''클로스트리디오이데스 디피실'' (''Clostridioides difficile'')
클린다마이신은 항생제 내성을 가진 ''클로스트리디오이데스 디피실''의 과도한 증식을 유발할 수 있으며, 이는 설사에서 독성 거대 결장에 이르기까지 다양한 부작용을 일으키는 독소 생성을 초래한다.[43][46]과거에는 위막성 장염의 주요 원인으로 알려졌으나, 현재는 다른 항생제에서도 비슷한 빈도로 발생한다는 사실이 밝혀져 굳이 강조되지는 않는다. 클린다마이신은 쓴맛이 강해 소아에게 사용하기 어렵다.
4. 상호작용
클린다마이신은 신경근 차단제인 석시닐콜린, 베쿠로늄 등의 효과를 연장시킬 수 있다.[53][54][55] 마크로라이드, 클로람페니콜과 작용 기전이 유사하므로 동시에 투여해서는 안 되며, 이는 길항 작용[24] 및 교차 내성을 유발할 수 있다.
5. 약리 작용
클린다마이신은 주로 세균 정지 효과를 나타낸다. 더 높은 농도에서는 살균 효과를 보일 수 있다.[60] 단백질 생합성 억제제로, 마크로라이드와 유사하게 리보솜 전위를 억제하여 작용한다.[61] 세균의 50S 리보솜 소단위체의 rRNA에 결합하여 작용하며, 이는 옥사졸리디논, 플레로뮤틸린, 마크로라이드 항생제의 결합 부위와 겹친다.[62][63] 이러한 결합은 가역적이다.[64] 클린다마이신은 린코마이신보다 효과적이다.[60]
클린다마이신이 리보솜(또는 리보솜 소단위체)에 결합된 X선 결정 구조는 ''대장균''(Escherichia coli),[65] ''데오비브리오 방사내성균''(Deinococcus radiodurans),[66] 및 ''할로아르쿨라 마리스모르투이''(Haloarcula marismortui)[67]에서 밝혀졌다. 또한, 밀접하게 관련된 항생제인 린코마이신이 ''황색포도상구균''(Staphylococcus aureus)의 50S 리보솜 소단위체에 결합된 구조도 보고되었다.[68] 리보솜의 50S 서브유닛을 억제하여 세균의 단백질 합성을 억제한다. 단백질 합성 억제제로서 작용 기전은 마크로라이드계 항생물질과 같지만, 화학적 구조는 전혀 다르다.
6. 화학적 합성
클린다마이신은 반합성 유도체로, 방선균의 일종인 ''Streptomyces lincolnensis''에 의해 생성되는 천연 항생제인 린코마이신에서 유래한다. 린코마이신의 7(''R'')-수산기를 7(''S'')-클로로-치환 반응으로 치환하여 얻는다.[57][58] 1966년 제5회 항균제 및 화학요법에 관한 학술회의(ICAAC)에서 BJ 매걸린, RD 비르켄마이어, F 케이건이 처음으로 클린다마이신의 합성을 발표했으며,[59] 1968년부터 시판되었다.[44]
클린다마이신은 물에 매우 잘 녹는 흰색 또는 노란색 가루이다.[60] 국소적으로 사용되는 클린다마이신 인산염은 클린다마이신의 인산 에스터 전구약물이다.[56]
7. 사회와 문화
Clindamycin영어은 제네릭 의약품으로 이용 가능하며 비교적 가격이 저렴하다.[13][69]
7. 1. 이용 가능한 형태
클린다마이신은 경구, 질, 국소 투여 등 다양한 형태로 이용 가능하다.[30][37][70]
클린다마이신 경구 제제에는 클린다마이신 염산염을 함유한 캡슐과 클린다마이신 팔미테이트 염산염을 함유한 경구 현탁액이 있다.[30] 경구 현탁액은 맛과 냄새가 매우 고약하여 어린이에게는 선호되지 않는다.
클린다마이신은 세균성 질염 치료를 위해 질 크림과 질 좌제 형태로 제형화된다.[37] 또한 겔, 로션, 폼, 에탄올 용액 형태로 국소 투여가 가능하며, 주로 여드름 치료 처방에 사용된다.[70]
클린다마이신이 함유된 여러 복합 여드름 치료제도 시판되고 있다. 예를 들어 클린다마이신과 벤조일 과산화물 단일 제품 제형인 BenzaClin (사노피-아벤티스), Duac (Stiefel에서 제조한 겔 형태), Acanya 등이 있다. 미국에서는 클린다마이신과 트레티노인의 조합인 Ziana가 판매된다.[71] 인도에서는 클린다마이신과 클로트리마졸을 조합한 질 좌제가 Clinsup-V로 판매된다. 이집트에서는 클린다마이신 질 크림이 Vagiclind로 판매되어 질염에 사용된다.
클린다마이신은 전신(경구 및 정맥) 및 국소 사용 모두에 대해 제네릭 의약품으로 제공된다.[30] (예외는 미국에서 제네릭으로 제공되지 않는 질 좌약이다.[72])
7. 2. 경제성
클린다마이신은 제네릭 의약품으로 이용 가능하며 비교적 저렴하다.[13][69]8. 수의학적 사용
클린다마이신은 수의학에서 사람과 매우 비슷하게 골수염,[73] 피부 감염, 톡소플라스마증 치료에 사용된다. 특히 개와 고양이에게 톡소플라스마증의 우선적인 치료제이다.[74] 경구 투여 및 국소 투여 모두 가능하다.[60] 단점으로는 세균 저항성이 비교적 빠르게 생길 수 있고, 위장 장애 또한 발생할 수 있다는 점이다.[60] 톡소플라스마증은 고양이에게서 드물게 증상을 유발하지만, 매우 어린 새끼 고양이 또는 면역 결핍 고양이에게서 증상이 나타날 수 있다.
참조
[1]
drugs.com
[2]
웹사이트
Product monograph brand safety updates
https://www.canada.c[...]
2024-06-06
[3]
웹사이트
Clindamycin (Systemic)
https://www.drugs.co[...]
The American Society of Health-System Pharmacists
2021-12-19
[4]
논문
Clinical practice. Skin and soft-tissue infections caused by methicillin-resistant Staphylococcus aureus
2007-07
[5]
웹사이트
Xaciato- clindamycin phosphate gel
https://dailymed.nlm[...]
2021-12-24
[6]
서적
Hidradenitis suppurativa
https://books.google[...]
Springer
2006
[7]
웹사이트
Clindamycin phosphate- clindamycin phosphate gel usp, 1% gel
https://dailymed.nlm[...]
2021-12-19
[8]
간행물
Daré Announces FDA Approval of Xaciato (clindamycin phosphate) Vaginal Gel as a Treatment for Bacterial Vaginosis
https://darebioscien[...]
2021-12-07
[9]
논문
Antibiotics and hospital-acquired Clostridium difficile-associated diarrhoea: a systematic review
[10]
논문
Current indications for the use of clindamycin: A critical review
1998-01
[11]
서적
Neonatal Formulary: Drug Use in Pregnancy and the First Year of Life
https://books.google[...]
John Wiley & Sons
2014
[12]
서적
World Health Organization model list of essential medicines: 22nd list (2021)
World Health Organization
[13]
서적
Tarascon Pocket Pharmacopoeia 2015 Deluxe Lab-Coat Edition
Jones & Bartlett Learning
2015
[14]
웹사이트
Competitive Generic Therapy Approvals
https://www.fda.gov/[...]
2023-06-29
[15]
웹사이트
The Top 300 of 2022
https://clincalc.com[...]
2024-08-30
[16]
웹사이트
Clindamycin Drug Usage Statistics, United States, 2013 - 2022
https://clincalc.com[...]
2024-08-30
[17]
논문
Clindamycin in dentistry: more than just effective prophylaxis for endocarditis?
2005-11
[18]
웹사이트
Cleocin I.V. Indications & Dosage
http://www.rxlist.co[...]
RxList.com
2007-12-01
[19]
논문
Antibiotic treatment of gram-positive bone and joint infections
[20]
논문
Diagnosis and treatment of acne
https://www.aafp.org[...]
2004-05
[21]
논문
Acne Vulgaris: Diagnosis and Treatment
https://www.aafp.org[...]
2019-10
[22]
논문
Meta-analysis comparing efficacy of benzoyl peroxide, clindamycin, benzoyl peroxide with salicylic acid, and combination benzoyl peroxide/clindamycin in acne
2010-07
[23]
논문
Anaerobic bloodstream infections in Italy (ITANAEROBY): A 5-year retrospective nationwide survey
2022-06
[24]
웹사이트
Clindamycin: new look at an old drug
http://www.pediatric[...]
2005-01
[25]
서적
Clinical infectious diseases: a practical approach
Oxford University Press
[26]
논문
Antimicrobial treatment of ''Capnocytophaga'' infections
2007-04
[27]
웹사이트
Clindamycin Phosphate Susceptibility and Minimum Inhibitory Concentration (MIC) Data
https://www.toku-e.c[...]
2020-06-01
[28]
논문
Mechanisms of Resistance to Macrolides and Lincosamides: Nature of the Resistance Elements and Their Clinical Implications
2002-02
[29]
논문
Macrolide-inducible resistance to clindamycin and the D-test
2009-12
[30]
논문
Clindamycin as an antimalarial drug: review of clinical trials
[31]
논문
Treatment of malaria in the United States: a systematic review
[32]
논문
Genome scanning of Amazonian Plasmodium falciparum shows subtelomeric instability and clindamycin-resistant parasites
[33]
논문
Managing toxic shock syndrome with antibiotics
[34]
논문
Targeting bacterial virulence: the role of protein synthesis inhibitors in severe infections. Insights from the Society of Infectious Diseases Pharmacists
2003-05
[35]
논문
Regulation of protein A biosynthesis in Staphylococcus aureus by certain antibiotics: its effect on phagocytosis by leukocytes
[36]
논문
Potentiation of opsonization and phagocytosis of Streptococcus pyogenes following growth in the presence of clindamycin
1981-05
[37]
논문
Can antibiotics prevent preterm birth—the pro and con debate
[38]
논문
Babesiosis
2000-07
[39]
논문
Okuläre Toxoplasmose
[40]
논문
Intérêt de la clindamycine dans le traitement de la toxoplasmose oculaire
[41]
논문
Treatment of infection due to Pneumocystis carinii
1998-06
[42]
논문
Hidradenitis Suppurativa: Advances in Diagnosis and Treatment
2017-11
[43]
서적
Australian Medicines Handbook
AMH Pty Ltd
2006
[44]
논문
Clindamycin and taste disorders
2007-10
[45]
논문
Clostridium difficile associated diarrhoea: diagnosis and treatment
[46]
논문
Clostridium difficile colitis
1994-01
[47]
논문
Clindamycin as an antimalarial drug: review of clinical trials
2002-08
[48]
논문
Transfer of drugs and other chemicals into human milk
2001-09
[49]
서적
Breastfeeding and maternal medication : recommendations for drugs in the Eleventh WHO Model List of Essential Drugs
World Health Organization
2002
[50]
서적
Medications & mothers' milk
Springer
[51]
논문
Excretion of antimicrobials used to treat methicillin-resistant Staphylococcus aureus infections during lactation: safety in breastfeeding infants
2009-09
[52]
논문
Clindamycin
https://www.ncbi.nlm[...]
National Library of Medicine (US)
2006
[53]
논문
Prolongation of a pancuronium-induced neuromuscular blockade by clindamycin
[54]
논문
Clindamycin-induced neuromuscular blockade
[55]
논문
Prolongation of rapacuronium neuromuscular blockade by clindamycin and magnesium
[56]
웹사이트
Clindamycin Phosphate Topical Solution
https://www.rxlist.c[...]
2017-01-27
[57]
논문
Lincomycin. XI. Synthesis and structure of clindamycin, a potent antibacterial agent
1970-07
[58]
논문
Microbiological and Pharmacological Behavior of 7-Chlorolincomycin
[59]
논문
Chemical modification of lincomycin
[60]
논문
Lincomycin, clindamycin and their applications
2004-05
[61]
웹사이트
Clindamycin
https://archive.toda[...]
[62]
웹사이트
Lincosamides, Oxazolidinones, and Streptogramins
https://www.merckman[...]
Merck & Co.
2020-05
[63]
논문
Ribosome-targeting antibiotics and mechanisms of bacterial resistance
2014-01
[64]
문서
Beauduy CE, Winston LG. Tetracyclines, Macrolides, Clindamycin, Chloramphenicol, Streptogramins, & Oxazolidinones. In: Katzung BG. eds. Basic & Clinical Pharmacology, 14e New York, NY: McGraw-Hill; .
[65]
논문
Structures of the Escherichia coli ribosome with antibiotics bound near the peptidyl transferase center explain spectra of drug action
2010-10
[66]
논문
Structural basis for the interaction of antibiotics with the peptidyl transferase centre in eubacteria
2001-10
[67]
논문
Structures of MLSBK antibiotics bound to mutated large ribosomal subunits provide a structural explanation for resistance
2005-04
[68]
논문
Structural insights of lincosamides targeting the ribosome of Staphylococcus aureus
2017-09
[69]
서적
Infectious Diseases in Critical Care Medicine
https://books.google[...]
CRC Press
2009
[70]
논문
A randomized, double-blind comparison of a clindamycin phosphate/benzoyl peroxide gel formulation and a matching clindamycin gel with respect to microbiologic activity and clinical efficacy in the topical treatment of acne vulgaris
[71]
웹사이트
FDA Approvals: Ziana, Kadian, Polyphenon E
https://www.medscape[...]
2006-12-01
[72]
웹사이트
Generic Cleocin Vaginal Availability
https://www.drugs.co[...]
2019-10-13
[73]
웹사이트
Osteomyelitis
http://www.merckvetm[...]
John Wiley & Sons
2005-02-08
[74]
웹사이트
Toxoplasmosis: Introduction
http://www.merckvetm[...]
John Wiley & Sons
2005-02-08
[75]
간행물
日本医事新報
[76]
문서
お薬事典2019年版 監修:一色高明より
2019-07-16
[77]
논문
A randomized trial of clindamycin versus trimethoprim-sulfamethoxazole for uncomplicated wound infection
2016-03-29
[78]
웹인용
Clindamycin Hydrochloride
https://www.drugs.co[...]
The American Society of Health-System Pharmacists
2015-09-04
[79]
저널
Clinical practice. Skin and soft-tissue infections caused by methicillin-resistant Staphylococcus aureus
[80]
서적
Hidradenitis suppurativa
https://books.google[...]
Springer
2006
[81]
저널
Antibiotics and hospital-acquired Clostridium difficile-associated diarrhoea: a systematic review
http://jac.oxfordjou[...]
[82]
서적
Neonatal Formulary: Drug Use in Pregnancy and the First Year of Life
https://books.google[...]
John Wiley & Sons
2014
[83]
저널
Current indications for the use of clindamycin: A critical review
1998-01
[84]
웹인용
WHO Model List of Essential Medicines (19th List)
http://www.who.int/m[...]
2015-04
[85]
서적
Tarascon Pocket Pharmacopoeia 2015 Deluxe Lab-Coat Edition
Jones & Bartlett Learning
2015
[86]
웹인용
Clindamycin
http://mshpriceguide[...]
2015-09-06
[87]
웹인용
The Top 300 of 2019
https://clincalc.com[...]
2018-12-22
[88]
웹인용
Clindamycin Phosphate Topical Solution
http://www.rxlist.co[...]
RxList
2017-01-27
본 사이트는 AI가 위키백과와 뉴스 기사,정부 간행물,학술 논문등을 바탕으로 정보를 가공하여 제공하는 백과사전형 서비스입니다.
모든 문서는 AI에 의해 자동 생성되며, CC BY-SA 4.0 라이선스에 따라 이용할 수 있습니다.
하지만, 위키백과나 뉴스 기사 자체에 오류, 부정확한 정보, 또는 가짜 뉴스가 포함될 수 있으며, AI는 이러한 내용을 완벽하게 걸러내지 못할 수 있습니다.
따라서 제공되는 정보에 일부 오류나 편향이 있을 수 있으므로, 중요한 정보는 반드시 다른 출처를 통해 교차 검증하시기 바랍니다.
문의하기 : help@durumis.com
